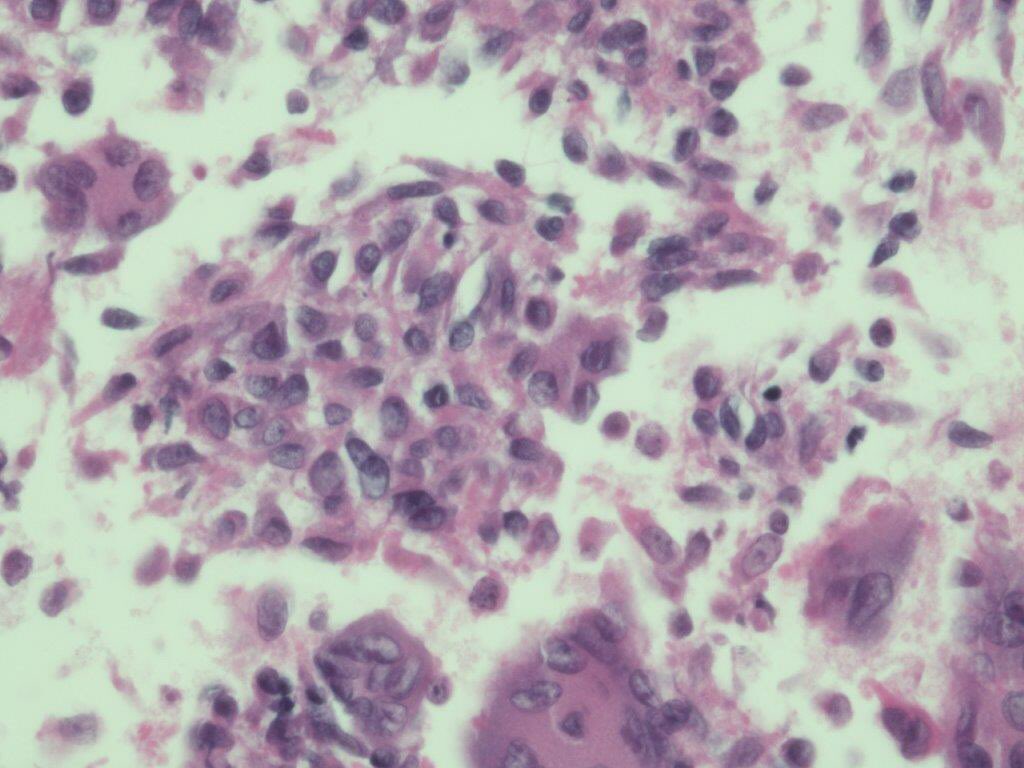
Giant cell tumor of the tendon sheath .The two components of tumor ie stromal cells and giant cells have similar nuclei . If hemosiderin laden macrophages are present ABC is in d/d #Cytopath #cytology #pathresidents #fnafriday #TemplePathology

Mazen Gafeer
@mazengh88
Cytopathology Fellow @ Weill Cornell
ID: 909122491834085376
16-09-2017 18:31:07
11 Tweet
33 Followers
60 Following


#breastpath Liza Quintana, MD Jenny Pincus, MD Breast Pathology ISBP #pathresidents #pathboards Classic text book picture of a mass in a young women in 20s related to pregnancy. See secretions in lumina n cytoplasmic vacuolation


Perfect example of FEA >>ADH Fnu Sakshi/Sakshi Gupta #pathresidents toto eshmela Nikolina Dioufa Anu Peter, MD Mazen Gafeer

Moving forward—the 2019 ASCCP Risk-Based Management Consensus Guidelin... sciencedirect.com/science/articl… Great read Ritu Nayar, MD Cytopathology.org Journal of American Society of Cytopathology

Spectrum of changes from Flat epithelial atypia to ADH bordering to low grade DCIS #breastpath ISBP Liza Quintana, MD Alexander Damron, MD Reza Eshraghi Brian McMillen MD Jenny Pincus, MD Edi Brogi Yaileen D. Guzmán-Arocho, MD Fnu Sakshi/Sakshi Gupta toto eshmela Mazen Gafeer Marcos Lepe, MD Olaleke Folaranmi Temple Path


Jerad Gardner, MD Very useful video . Will tag my residents Mazen Gafeer Fnu Sakshi/Sakshi Gupta Nikolina Dioufa Anu Peter, MD toto eshmela Lakshmi R Nair